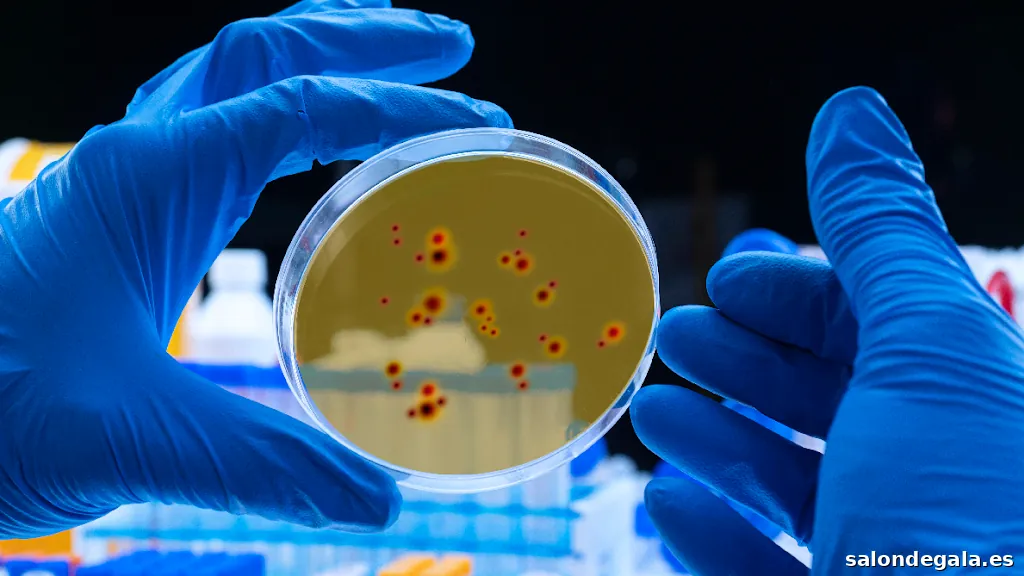
digicomphoto

Capturando momentos mágicos para toda la eternidad. Nuestro lente, tu historia. Cada imagen es un recuerdo, cada disparo una emoción. Deja que nuestro arte inmortalice tu día especial. Descubre la belleza en cada detalle a través de nuestros ojos. Bodas que perduran en imágenes, para siempre.
Las cookies analíticas se utilizan para comprender cómo interactúan los visitantes con el sitio web. Estas cookies ayudan a proporcionar información sobre métricas el número de visitantes, el porcentaje de rebote, la fuente de tráfico, etc.
Usamos cookies para mejorar su experiencia de navegación, mostrarle anuncios o contenidos personalizados y analizar nuestro tráfico. Al hacer clic en “Aceptar todo” usted da su consentimiento a nuestro uso de las cookies.
Dos historias, un solo cuadro.Dos Serán Unoeterniza momentos especiales en una imagen inolvidable. Nuestra pasión es capturar la esencia de tus momentos más especiales y convertirlos en una única imagen inolvidable.
Usamos cookies para ayudarle a navegar de manera eficiente y realizar ciertas funciones. Encontrará información detallada sobre cada una de las cookies bajo cada categoría de consentimiento a continuación.
Las cookies necesarias son cruciales para las funciones básicas del sitio web y el sitio web no funcionará de la forma prevista sin ellas. Estas cookies no almacenan ningún dato de identificación personal.
Las cookies funcionales ayudan a realizar ciertas funcionalidades, como compartir el contenido del sitio web en plataformas de redes sociales, recopilar comentarios y otras características de terceros.
Las cookies de rendimiento se utilizan para comprender y analizar los índices de rendimiento clave del sitio web, lo que ayuda a proporcionar una mejor experiencia de usuario para los visitantes.
Las cookies publicitarias se utilizan para entregar a los visitantes anuncios personalizados basados en las páginas que visitaron antes y analizar la efectividad de la campaña publicitaria.
Las cookies categorizadas como “Necesarias” se guardan en su navegador, ya que son esenciales para permitir las funcionalidades básicas del sitio web....Mostrar más
Características:
Acceso para sillas de ruedasServicios:
Estudio de fotografíaHorario de apertura:
El horario podría no estar actualizado. Contacte con X para asegurarse.
Nuestra opinión desde salondegala.es sobre Dos Serán Uno
La empresa "Dos Serán Uno" se destaca por su enfoque en la captura de momentos especiales y la creación de recuerdos eternos a través de la fotografía. Los clientes destacan la profesionalidad y la pasión del propietario, quien se esfuerza por entender y reflejar la esencia de cada boda de manera única y natural.
La atención al detalle y la capacidad para capturar los momentos más significativos son aspectos que los clientes valoran especialmente. La empresa ofrece un servicio personalizado y flexible, adaptándose a las necesidades y preferencias de cada pareja.
La calidad de las fotografías es otro aspecto que se destaca, con clientes que describen las imágenes como "elegantes", "únicas" y "con buen gusto". La capacidad del fotógrafo para crear un ambiente relajado y natural durante las sesiones de fotografía también es mencionada como un punto fuerte.
En general, la empresa "Dos Serán Uno" parece tener un enfoque centrado en el cliente, con un propietario que se esfuerza por entender y satisfacer las necesidades de cada pareja. La combinación de profesionalidad, pasión y atención al detalle hace que esta empresa sea una opción atractiva para aquellos que buscan un fotógrafo de bodas en Jaén.
salondegala.es no puede garantizar que los profesionales y empresas que aparecen en el directorio tengan la formación ni las certificaciones adecuadas. La mayoría de empresas que aparecen en el directorio son profesionales de gran reputación. Te recomendamos solicitar el número de colegiado del profesional al que vayas a asistir a realizar tu tratamiento o consulta.
4.9 (13 opiniones)
0 opiniones
0 opiniones
0 opiniones
1 opiniones
12 opiniones
Hernan David Gutierrez Acevedo
hace 11 meses - 5 (Experiencia positiva)
Excelente servicio de parte del propietario, rapido y agil
Respuesta de Dos Serán Uno
Gracias Hernán David. Tus palabras nos ayudan a seguir creciendo.
Tomas Iñiguez Tauste
hace 4 años - 5 (Experiencia positiva)
Gran profesional, se nota que le apasiona su trabajo!
Respuesta de Dos Serán Uno
Gracias Tomás. Se agradecen comentarios cómo el tuyo.
Rafael Marquez
hace 4 años - 4 (Experiencia positiva)
Puri Martinez
hace 6 años - 5 (Experiencia positiva)
Hemos quedado encantados con el reportaje de nuestra boda. Tanto preboda, boda y postboda reflejan los momentos más especiales de estos meses. Sin duda, Blas es un profesional de la fotografía que ha conseguido captar cada detalle, y lo más importante, de una forma natural y muy espontánea. Recomendable totalmente. Jose y Puri
Manuel L. Caballero
hace 6 años - 5 (Experiencia positiva)
ainhoa rebollo
hace 6 años - 5 (Experiencia positiva)
Un trato muy cercano y profesional. Fotos únicas. Repetiremos seguro
ICC ICC
hace 6 años - 5 (Experiencia positiva)
¡Excelente profesional! 100% recomendables sus servicios. Paciente, flexible e innovador en cada uno de sus trabajos. Gracias por haber capturado cada segundo del día más feliz de mi vida 😃
Pedro Nagera
hace 6 años - 5 (Experiencia positiva)
Fotografía elegante y con buen gusto. Blas es un auténtico profesional y excelente persona. Sin duda volvería a contratar sus servicios.
Maria Cueva Ortega
hace 6 años - 5 (Experiencia positiva)
Super recomendable, se adapta a los novios en todo momento. Es capaz de captar los momentos más bonitos e importantes!
Mari Carmen Parras Garrido
hace 6 años - 5 (Experiencia positiva)
Cinco estrellas se me quedan cortas para poder dar mi opinión sobre Dos serán Uno, Blas Castellanos. Un fotógrafo de la cabeza a los pies que hizo un trabajo magnífico el día de nuestra boda. El resultado fue genial, volvería a contratarlo y siempre que necesite temas de fotografía espero poder contar con el. Para mi marido y para mí, es el mejor.
Pedro Mon
hace 6 años - 5 (Experiencia positiva)
Dos serán uno, es Blás. Un maravilloso profesional de la fotografía y una gran persona que se implicará desde el primer segundo con tu proyecto. Absolutamente recomendable. Si buscas un fotógrafo en Jaén, acertarás.
Alvaro Sancha
hace 6 años - 5 (Experiencia positiva)
Blas, gran persona que está detrás de esta bonita empresa llamada Dos serán uno. Gran profesional. Flexible, puntual, calidad desde el minuto uno. Un gran fotógrafo de bodas en Jaén! 100% recomemdado
Paquimc
hace 7 años - 5 (Experiencia positiva)
Deja tu opinión sobre Dos Serán Uno
Añade tu empresa a nuestro directorio de forma gratuita
Si eres un fotógrafo o tienes un estudio fotográfico y quieres aparecer en nuestra guía, envíanos la información de tu empresa y podrás aparecer de forma totalmente gratuita.
 4.9 (13)
4.9 (13)
Ver dirección y datos de contacto
 4.8 (30)
4.8 (30)
Ver dirección y datos de contacto
 4.8 (4)
4.8 (4)
Ver dirección y datos de contacto
 1 (1)
1 (1)
Ver dirección y datos de contacto
0 (0)
0 (0)
Ver dirección y datos de contacto